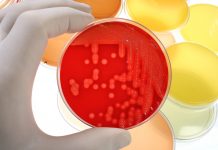
Zagrożenia mikrobiologiczne w gabinetach kosmetycznych

BB Glow Skin – HIT CZY KIT?
Od zarania dziejów kobiety na całym świecie szukały sposobu na to, aby jak najdłużej zachować młody i piękny wygląd. Nieskazitelna i promienna cera to do...
Blizny potrądzikowe – mechanizm powstawania i diagnostyka
Streszczenie
Trądzik to choroba skóry, powszechnie występująca wśród nastolatków oraz osób dorosłych. Dermatoza ta może pozostawić defekty na skórze w postaci blizn. Wyróżnia się kilka rodzajów blizn potrądzikowych, których...
Zmiany barwnikowe paznokci. Diagnostyka różnicowa i postępowanie
Streszczenie
Zmiany barwnikowe paznokci stanowią niemały problem diagnostyczny nie tylko dla lekarzy, ale również dla personelu gabinetów kosmetycznych. Często to manikiurzystki są pierwszymi osobami, które zauważają zmiany paznokci i...
Retinoidy. Mechanizm działania, właściwości oraz zakres stosowania w dermatologii i kosmetologii
Streszczenie
Retinoidy stanowią szeroką grupę związków zawierającą witaminę A, jej pochodne oraz inne związki aktywujące receptory retinoidowe.
Celem pracy było przedstawienie mechanizmu działania, właściwości retinoidów oraz ich zastosowanie w leczeniu...
Epidermoliza jako powikłanie po peelingu 45% kwasem pirogronowym. Opis przypadku
Streszczenie
Peeling chemiczny kwasem pirogronowym jest polecany w przypadku rogowacenia mieszkowego. Mimo że zabieg uważany jest za stosunkowo bezpieczny, może skutkować wystąpieniem trudno poddającego się leczeniu powikłaniu, jakim jest...
Zagrożenia mikrobiologiczne w gabinetach kosmetycznych
Streszczenie
Świadomość na temat możliwych zagrożeń epidemiologicznych w gabinetach kosmetycznych w ostatnich latach znacznie wzrosła. Jest to zasługa zarówno właścicieli, jak i pracowników salonów, którzy wprowadzają nowe wymogi z...
Świadomość społeczeństwa na temat wykorzystania oleju konopnego
Streszczenie
Konopie siewne, nazywane włóknistymi, to roślina, wykazująca duże właściwości adaptacyjne do różnych warunków geograficznych, klimatycznych i glebowych. Wytwarza ona kannabinoidy związki o działaniu halucynogennym, ale i też leczniczym. Znajduje...
Rola kosmetologa w diagnostyce oraz terapii nowotworowej
Streszczenie
Na całym świecie obserwuje się wzrost zachorowań na nowotwory złośliwe. W czasach intensywnych poszukiwań nowych, bardziej skutecznych i mniej wyniszczających metod leczenia oraz diagnostyki dużą rolę odgrywa również...